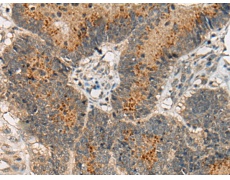
一抗

|
Background: |
USP32 (ubiquitin specific peptidase 32), also known as NY-REN-60, is a 1,604 amino acid protein that contains one DUSP domain and three EF-hand calcium binding domains. Localized to membranes in a lipid-anchored fashion and expressed in all normal tissues, USP32 catalyzes the conversion of a ubiquitin C-terminal thioester to a free ubiquitin and a thiol, a reaction that may influence several cellular processes. |
|
Applications: |
ELISA, IHC |
|
Name of antibody: |
USP32 |
|
Immunogen: |
Fusion protein of human USP32 |
|
Full name: |
ubiquitin specific peptidase 32 |
|
Synonyms: |
USP10; NY-REN-60 |
|
SwissProt: |
Q8NFA0 |
|
ELISA Recommended dilution: |
5000-10000 |
|
IHC positive control: |
Human liver cancer and human cervical cancer |
|
IHC Recommend dilution: |
50-300 |


 購(gòu)物車
購(gòu)物車 幫助
幫助
 021-54845833/15800441009
021-54845833/15800441009